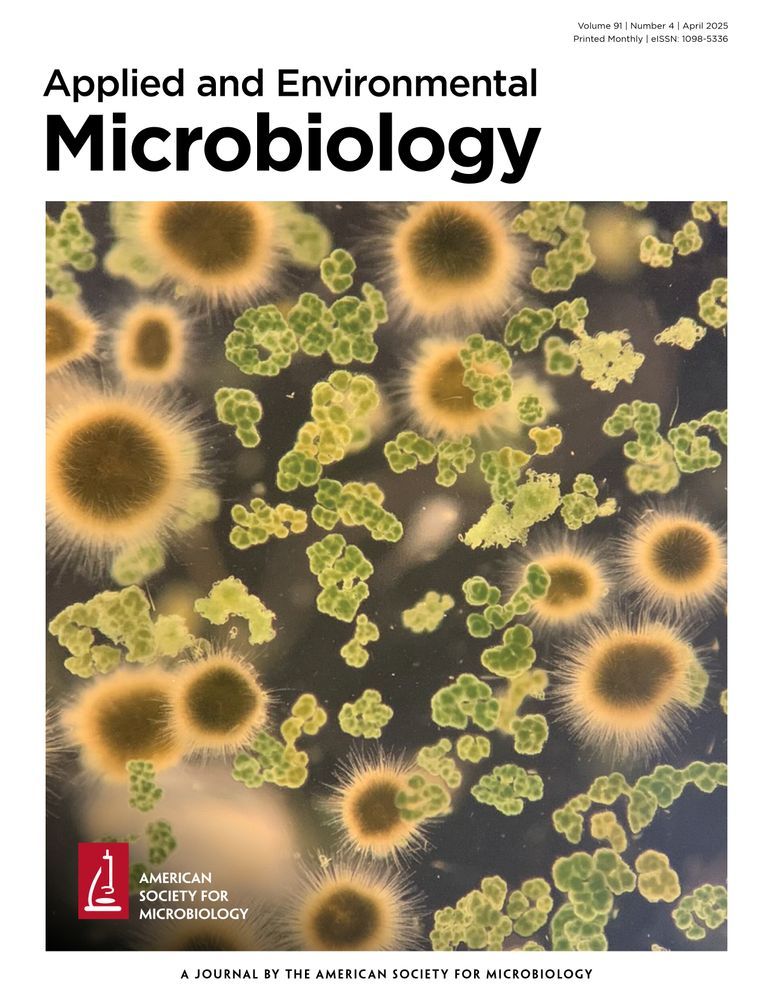

seva-plasmids.com

Contribute your own constructs to our open plasmid repository and help make #SynBio more reproducible for everyone.
✨ Check out our contribution guidelines and join the mission!👇👇
seva-plasmids.com

Contribute your own constructs to our open plasmid repository and help make #SynBio more reproducible for everyone.
✨ Check out our contribution guidelines and join the mission!👇👇
seva-plasmids.com
👉 doi.org/10.1101/2025...

👉 doi.org/10.1101/2025...


Researchers at Micalis Institute present a phagemid toolbox —with #SEVA-based variants— for DNA delivery and next-gen multicellular circuits.
👉 doi.org/10.1101/2025...

Researchers at Micalis Institute present a phagemid toolbox —with #SEVA-based variants— for DNA delivery and next-gen multicellular circuits.
👉 doi.org/10.1101/2025...
This review explores devices from switches & logic gates to memory modules, powering circuits for bioproduction, therapeutics & biosafety — maybe you’ll find the ideal one for your research 👉 doi.org/10.3389/fsyb...

This review explores devices from switches & logic gates to memory modules, powering circuits for bioproduction, therapeutics & biosafety — maybe you’ll find the ideal one for your research 👉 doi.org/10.3389/fsyb...
It’s built around 3 fundamental modules:
1️⃣ Origin of replication
2️⃣ Selection marker
3️⃣ Cargo
With this open standard, you can design predictable and efficient genetic systems in bacteria and yeast.
👉 Learn more here:
seva-plasmids.com

It’s built around 3 fundamental modules:
1️⃣ Origin of replication
2️⃣ Selection marker
3️⃣ Cargo
With this open standard, you can design predictable and efficient genetic systems in bacteria and yeast.
👉 Learn more here:
seva-plasmids.com
That’s the question Cholpisit Kiattisewee explores in his review on multi-plasmid systems and their impact on #SynBio. And yes, #SEVA is part of the debate 👀
👉 Read the full article: doi.org/10.1098/rsob...

That’s the question Cholpisit Kiattisewee explores in his review on multi-plasmid systems and their impact on #SynBio. And yes, #SEVA is part of the debate 👀
👉 Read the full article: doi.org/10.1098/rsob...
Still don't know the basic design of a SEVA plasmid?
🧩 Combine modular parts and get your own standard plasmid from @SEVAplasmids for free.
Find your match here 👇
seva-plasmids.com

Still don't know the basic design of a SEVA plasmid?
🧩 Combine modular parts and get your own standard plasmid from @SEVAplasmids for free.
Find your match here 👇
seva-plasmids.com
That’s why @SEVAplasmids created a universal framework for plasmid vector design. Explore it here 👇
seva-plasmids.com

That’s why @SEVAplasmids created a universal framework for plasmid vector design. Explore it here 👇
seva-plasmids.com
👉 doi.org/10.1038/s414...

👉 doi.org/10.1038/s414...
@norholm.bsky.social's lab created a new plasmid recombination system in E. coli using SEVAplasmids. Compatible with any copy number, they expand the standardised toolbox for #SynBio 👉 doi.org/10.1038/s420...

@norholm.bsky.social's lab created a new plasmid recombination system in E. coli using SEVAplasmids. Compatible with any copy number, they expand the standardised toolbox for #SynBio 👉 doi.org/10.1038/s420...
👉 Discover @SEVAplasmids — a community-driven, non-profit collection of standardised plasmids.
🔬 Open, reliable, and ready for your research.
Check it out here 👇
seva-plasmids.com

👉 Discover @SEVAplasmids — a community-driven, non-profit collection of standardised plasmids.
🔬 Open, reliable, and ready for your research.
Check it out here 👇
seva-plasmids.com
1️⃣fewer copies
2️⃣more protein-coding
3️⃣more metabolic genes
And with gradual adoption of chromosome-like features as they become longer. For more details 👉 doi.org/10.1038/s414...

1️⃣fewer copies
2️⃣more protein-coding
3️⃣more metabolic genes
And with gradual adoption of chromosome-like features as they become longer. For more details 👉 doi.org/10.1038/s414...


1️⃣ Design your plasmid
2️⃣ Fill in the super simple order form
That’s it —your customised plasmids will be shipped straight to your lab 🚀 at no cost
Start now👉 seva-plasmids.com/contact/

1️⃣ Design your plasmid
2️⃣ Fill in the super simple order form
That’s it —your customised plasmids will be shipped straight to your lab 🚀 at no cost
Start now👉 seva-plasmids.com/contact/



✅ Antibiotic resistance marker
✅ Origins of replication
✅ Cargo modules for your experiment
Build your reproducible #SynBio project here👉 seva-plasmids.com

✅ Antibiotic resistance marker
✅ Origins of replication
✅ Cargo modules for your experiment
Build your reproducible #SynBio project here👉 seva-plasmids.com


